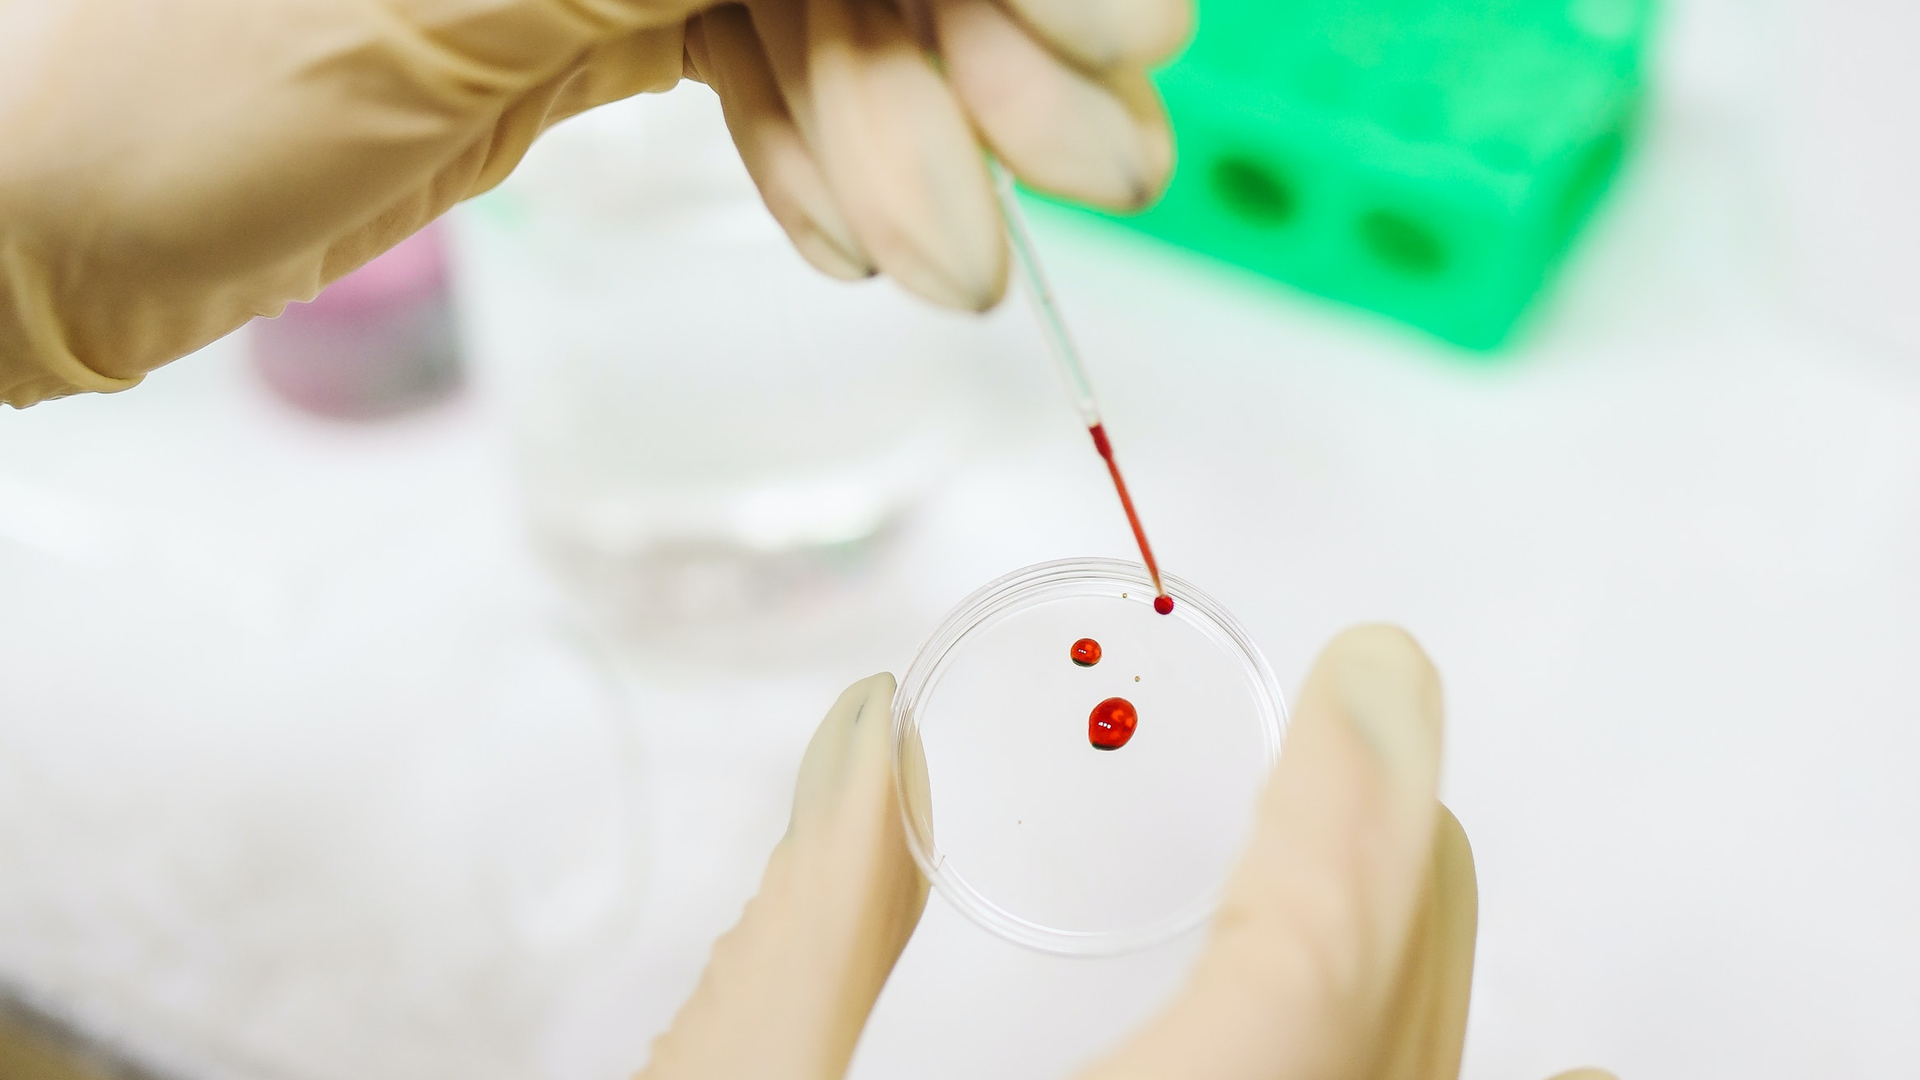
Photo by Polina Tankilevitch from Pexels

FDA updates data on serology test performance
The U.S. Food and Drug Administration (FDA) issued updated guidance on the serology tests, which detect the presence of antibodies in the blood from the body’s adaptive immune response to an infection, like COVID-19.
FDA continued:
The tests do not detect the virus itself. In the early days of an infection when the body's adaptive immune response is still building, antibodies may not be detected. This limits the test's effectiveness for diagnosing current COVID-19 and is one reason serology tests should not be used to diagnose or exclude acute COVID-19 infection.
Serology tests play a role in the fight against COVID-19 by helping healthcare professionals identify individuals who may have developed an adaptive immune response to SARS-CoV-2. However, to use serology tests properly, it is important to understand their performance characteristics and limitations. Moreover, studies are underway to address questions that will better inform the appropriate use of these tests, such as which antibodies may indicate a level of protection that would prevent or reduce the severity of infection or re-infection as well as the duration for which this protection may last.
The performance of these tests is described by their "sensitivity," or their ability to identify those with antibodies to SARS-CoV-2 (true positive rate), and their "specificity," or their ability to identify those without antibodies to SARS-CoV-2 (true negative rate). A test's sensitivity can be estimated by determining whether or not it is able to detect antibodies in blood samples from patients who have been confirmed to have COVID-19 with a nucleic acid amplification test, or NAAT. In some validation studies of these tests, like the one the FDA is conducting in partnership with the National Institutes of Health (NIH), the Centers for Disease Control and Prevention (CDC), and the Biomedical Advanced Research and Development Authority (BARDA), the samples used, in addition to coming from patients confirmed to have COVID-19 by a nucleic acid amplification test (NAAT), may also be confirmed to have antibodies present using other serology tests. A test's specificity can be estimated by testing large numbers of samples collected and frozen before SARS-CoV-2 is known to have circulated to demonstrate that the test does not produce positive results in response to the presence of other causes of a respiratory infection, such as other coronaviruses.
These estimates of sensitivity and specificity are just that: estimates. They include 95% confidence intervals, which are the range of estimates we are about 95% sure a test's sensitivity and specificity will fall within given how many samples were used in the performance validation. The more samples used to validate a test, the smaller the confidence interval becomes, meaning that we can be more confident in the estimates of sensitivity and specificity provided.
Tests are also described by their Positive and Negative Predictive values (PPV and NPV). These measures are calculated using a test's sensitivity, its specificity, and using an assumption about the percentage of individuals in the population who have antibodies to SARS-CoV-2 (which is called "prevalence" in these calculations). Every test returns some false positive and false negative results.
The PPV and NPV help those who are interpreting these tests understand, given how prevalent individuals with antibodies are in a population, how likely it is that a person who receives a positive result from a test truly does have antibodies to SARS-CoV-2 and how likely it is that a person who receives a negative result from a test truly does not have antibodies to SARS-CoV-2. The PPV and NPV of a test depend heavily on the prevalence of what that test is intended to detect. Because all tests will return some false positive and some false negative results, including tests that detect antibodies to SARS-CoV-2, broad use of the tests, when not appropriately informed by other relevant information, such as clinical history or diagnostic test results, could identify too many false-positive individuals.
The prevalence of SARS-CoV-2 antibody positive individuals varies across the United States, and prevalence is changing as the virus infects more individuals and as more individuals are vaccinated. In low prevalence populations, the result of a single antibody test is not likely to be sufficiently accurate to make an informed decision regarding whether or not an individual has had a prior infection or truly has antibodies to the virus. A second test, typically one assessing for the presence of antibodies to a different viral protein, generally would be needed to increase the accuracy of the overall testing results.
The FDA is also providing a calculator that will allow users to see the estimated performance of a single test or two independent tests based on their performance characteristics and the estimated prevalence of SARS-CoV-2 antibodies in the target population.